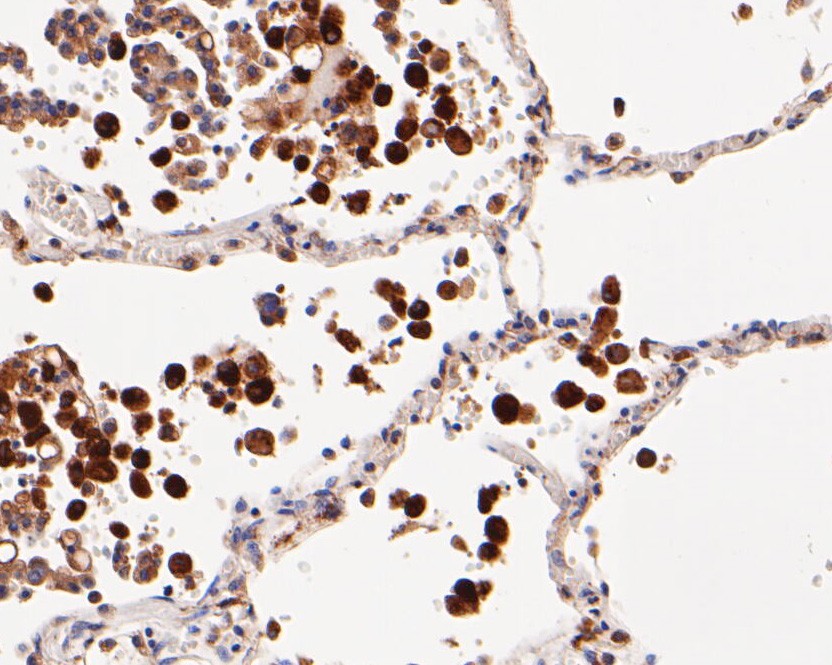
Fig4:; Immunohistochemical analysis of paraffin-embedded human lung tissue using anti-CD68 antibody. The section was pre-treated using heat mediated antigen retrieval with Tris-EDTA buffer (pH 8.0-8.4) for 20 minutes.The tissues were blocked in 5% BSA for 30 minutes at room temperature, washed with ddH; 2; O and PBS, and then probed with the primary antibody ( 1/200) for 30 minutes at room temperature. The detection was performed using an HRP conjugated compact polymer system. DAB was used as the chromogen. Tissues were counterstained with hematoxylin and mounted with DPX.

-
Product Name
Anti-CD68 antibody
- Documents
-
Description
Mouse monoclonal antibody to CD68
-
Tested applications
WB, IHC-P, FC
-
Species reactivity
Human
-
Alternative names
GP110 antibody; LAMP4 antibody; SCARD1 antibody
-
Isotype
IgG1
-
Preparation
This antigen of this antibody was synthetic peptide within human cd68 aa 320-354.
-
Clonality
Monoclonal
-
Formulation
Liquid, 1*PBS (pH7.4), 0.2% BSA, 50% Glycerol. Preservative: 0.05% Sodium Azide.
-
Storage instructions
Store at +4℃ after thawing. Aliquot store at -20℃. Avoid repeated freeze / thaw cycles.
-
Applications
WB:1:1,000-1:2,000
IHC-P:1:50-1:200
FC:1:50-1:100
-
Validations

Fig1:; Western blot analysis of CD68 on different lysates. Proteins were transferred to a PVDF membrane and blocked with 5% BSA in PBS for 1 hour at room temperature. The primary antibody ( 1/500) was used in 5% BSA at room temperature for 2 hours. Goat Anti-Mouse IgG - HRP Secondary Antibody (HA1001) at 1:5,000 dilution was used for 1 hour at room temperature.; Positive control:; Lane 1: A431 cell lysate; Lane 2: THP-1 cell lysate

Fig2:; Immunohistochemical analysis of paraffin-embedded human tonsil tissue using anti-CD68 antibody. The section was pre-treated using heat mediated antigen retrieval with Tris-EDTA buffer (pH 8.0-8.4) for 20 minutes.The tissues were blocked in 5% BSA for 30 minutes at room temperature, washed with ddH; 2; O and PBS, and then probed with the primary antibody ( 1/200) for 30 minutes at room temperature. The detection was performed using an HRP conjugated compact polymer system. DAB was used as the chromogen. Tissues were counterstained with hematoxylin and mounted with DPX.

Fig3:; Immunohistochemical analysis of paraffin-embedded human spleen tissue using anti-CD68 antibody. The section was pre-treated using heat mediated antigen retrieval with Tris-EDTA buffer (pH 8.0-8.4) for 20 minutes.The tissues were blocked in 5% BSA for 30 minutes at room temperature, washed with ddH; 2; O and PBS, and then probed with the primary antibody ( 1/200) for 30 minutes at room temperature. The detection was performed using an HRP conjugated compact polymer system. DAB was used as the chromogen. Tissues were counterstained with hematoxylin and mounted with DPX.
Fig4:; Immunohistochemical analysis of paraffin-embedded human lung tissue using anti-CD68 antibody. The section was pre-treated using heat mediated antigen retrieval with Tris-EDTA buffer (pH 8.0-8.4) for 20 minutes.The tissues were blocked in 5% BSA for 30 minutes at room temperature, washed with ddH; 2; O and PBS, and then probed with the primary antibody ( 1/200) for 30 minutes at room temperature. The detection was performed using an HRP conjugated compact polymer system. DAB was used as the chromogen. Tissues were counterstained with hematoxylin and mounted with DPX.

Fig5:; Flow cytometric analysis of CD68 was done on THP-1 cells. The cells were fixed, permeabilized and stained with the primary antibody ( 1/50) (red). After incubation of the primary antibody at room temperature for an hour, the cells were stained with a Alexa Fluor 488-conjugated Goat anti-Mouse IgG Secondary antibody at 1/1000 dilution for 30 minutes.Unlabelled sample was used as a control (cells without incubation with primary antibody; black).
- Background
-
References
- Wang L. et. al. Specific clinical and immune features of CD68 in glioma via 1,024 samples. Cancer Manag Res. 2018 Nov 27;10:6409-6419.
- Minami K. et. al. Prognostic significance of CD68, CD163 and Folate receptor-β positive macrophages in hepatocellular carcinoma. Exp Ther Med. 2018 May;15(5):4465-4476.
Related Products / Services
Please note: All products are "FOR RESEARCH USE ONLY AND ARE NOT INTENDED FOR DIAGNOSTIC OR THERAPEUTIC USE"
